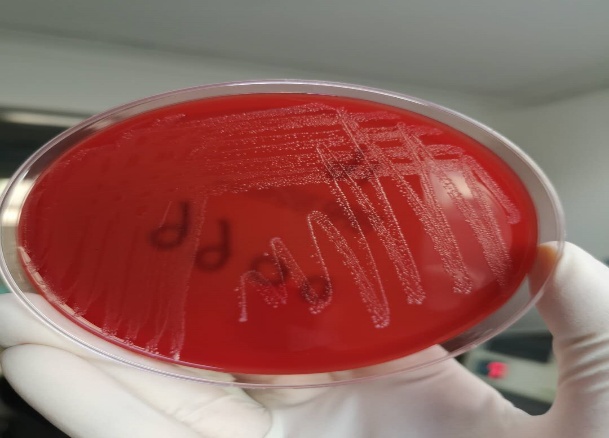
致死性B族链球菌感染,准妈妈不能忽视的产前筛查,你关注过吗?

随着国家对于围产期孕妇保健管理的不断增强,越来越多的产前筛查项目被列入公费医疗。最近几年,在大中型一线城市,致死性B族链球菌感染筛查已经列为孕产妇必查项目。致死性B族链球菌感染到底有多危险,请看今天为您带来的真实案例。
几天前,我们微生物实验室收到了临床送检一例出生仅1天的新生儿静脉血标本、咽拭子标本以及患儿母亲胎盘分泌物标本的培养,病例显示:其母亲无异常症状,自然分娩后新生儿神志清楚,足月外貌,但出生后不久出现鼻塞、吐沫、呼吸音粗,可闻及痰鸣音、心动过速、高热、精神反应差等一系列临床症状,高度可疑患儿是在母亲生产过程中发生了来自母体的感染,于是立即抽血培养送检。
第二天仪器监测界面提示有血培养报警,同时新生儿咽拭子、母亲胎盘培养阳性,菌落透明溶血形态相似,初步经验判断为无乳链球菌,后经质谱鉴定明确诊断,同时新生儿血液培养报阳,标本镜下涂片1000倍放大见G+球菌,(如下图所示),于是立即报给临床进行初始抗生素经验治疗,锁定母婴同时感染无乳链球菌,新生儿败血症诊断确立。

第三天实验室出具的抗生素敏感性报告与初始经验抗生素使用相一致,继续维持原抗生素方案不变,同时临床担心新生儿神经系统感染,日后留下后遗症,我们极其负责任的管床医生又进行了脑膜炎相关的脑脊液学检查,未发现阳性结果,评估新生儿诊断及时、预后良好,不会遗留后遗症,后经治疗新生儿症状逐渐好转,第六天遂痊愈全家高兴的出院了。
新生儿败血症( neonatal septicemia,neonatal sepsis)是指新生儿期细菌侵入血液循环并在其中生长繁殖、产生毒素所造成的全身感染。其发病率及病死率较高,尤其是早产儿及长期住院患儿,是临床医生在处理新生儿感染时最常考虑的诊断之一。近年国外新生儿败血症的发生率占全部活产婴的l‰~4‰,病死率高达17%~45%。国内新生儿败血症的发病率依不同医院而异,占活产儿的1‰~10‰,出生体重越轻,发病率越高,体重在1 000~1500 g者有的报告可高达164‰,可以看出新生儿一旦发生败血症,不仅死亡率增加,在整个抢救过程中,也将给整个家庭带来沉重的经济压力。

无乳链球菌,也称B族链球菌 (S.agalactiae)是乳腺炎的病原体,常存在于乳牛的皮肤、乳头及乳房内,通过挤乳人员的手或挤乳机械以及蝇类的机械携带而传播。这种链球菌引起乳房炎后不产生明显免疫力,目前尚无可靠的多价菌苗。
1938年Fry首次报告3例感染B族链球菌引起产后心内膜炎的死亡,证实B族链球菌为人类的致病菌。 经过几十年的研究,发现B族链球菌可引起新生儿败血症、肺炎、脑膜炎,甚至死亡。在感染后存活的新生儿,还有可能有严重的神经系统后遗症,包括脑积水、智力障碍、小头畸形、耳聋等。同时,B族链球菌还可引起孕妇感染、引起早产、胎儿发育不良(低体重儿)、胎膜早破及晚期流产。
正常情况下无乳链球菌是可以寄居于阴道和直肠,是一种条件致病菌,一般正常健康人群感染无乳链球菌并不致病。但是尽管对于孕产妇不致病,对于经产道自然分娩的新生儿却是可以致病的,据统计约10%~30%的孕妇有感染无乳链球菌,其中40%~70%在分娩过程中会传递给新生儿。如果新生儿带了这种菌,大约有1%~3%会出现早期侵入性感染,其中有5%会导致死亡,在新生儿败血症细菌检出种,无乳链球菌仅次于大肠埃希菌,排在第二位。

正因如此,在欧美国家围产期孕妇无乳链球菌筛查早就已经启动,我们国家最近几年也已经全面开展此项工作,根据大量研究数据显示怀孕第35~37周筛查该菌,检出率最高,此时制定抗生素治疗方案,完全可以确保胎儿分娩时不被感染。
生儿育女是每一个女人一生都要面临的问题,也是一个家庭的大事,为了生一个健康聪明的宝宝,B族链球菌筛查你做了吗?